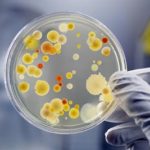

HOME
SERVICES
CONTACT
OUR SERVICES

RESEARCH & DEVELOPMENT
We base our developments in our clients different needs.

PRODUCT ANALYSIS
Our dedicated staff develop different kinds of formulation services according to our clients specifications.

ENGINEERING DEVELOPMENT
Our lab team has many years of reverse engineering experience and other formulation skills.

ENCAPSULATION

MICROBIOLOGICAL ANALYSIS
OUR SERVICES

RESEARCH & DEVELOPMENT
We base our developments on our clients’ specific needs.

PRODUCT ANALYSIS
Our dedicated staff develop different kinds of formulation services according to our clients specifications.

ENGINEERING DEVELOPMENT
Our lab team has many years of reverse engineering experience and other formulation skills.

ENCAPSULATION
Innovative Laboratories, Inc. manufactures only the highest quality of capsules with the highest quality material.
MICROBIOLOGICAL ANALYSIS
Innovative Laboratories, Inc. offers a variety of testing to assess microbiological contamination in consumable products.
WHO WE ARE

SEASONED PROS
Our professional staff includes MBAs, a certified sales process engineer, and a food scientist expert. We have special expertise in reverse engineering, formulation, and microbiological analysis.
WHO WE ARE

SEASONED PROS
Our professional staff includes MBAs, a certified sales process engineer, and a food scientist expert. We have special expertise in reverse engineering, formulation, and microbiological analysis.